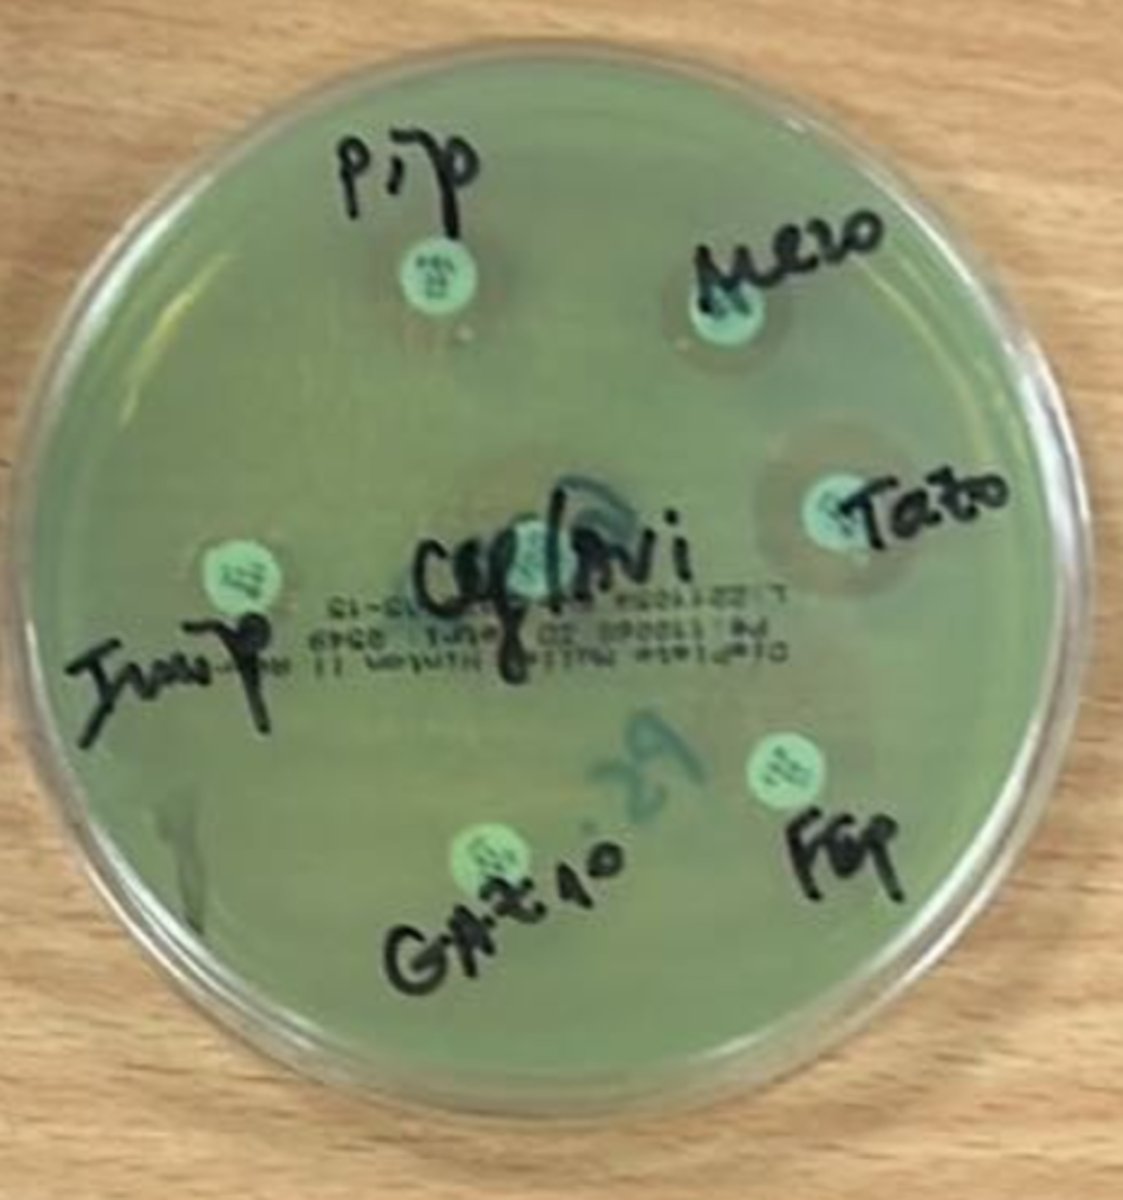
knowt flashcard image
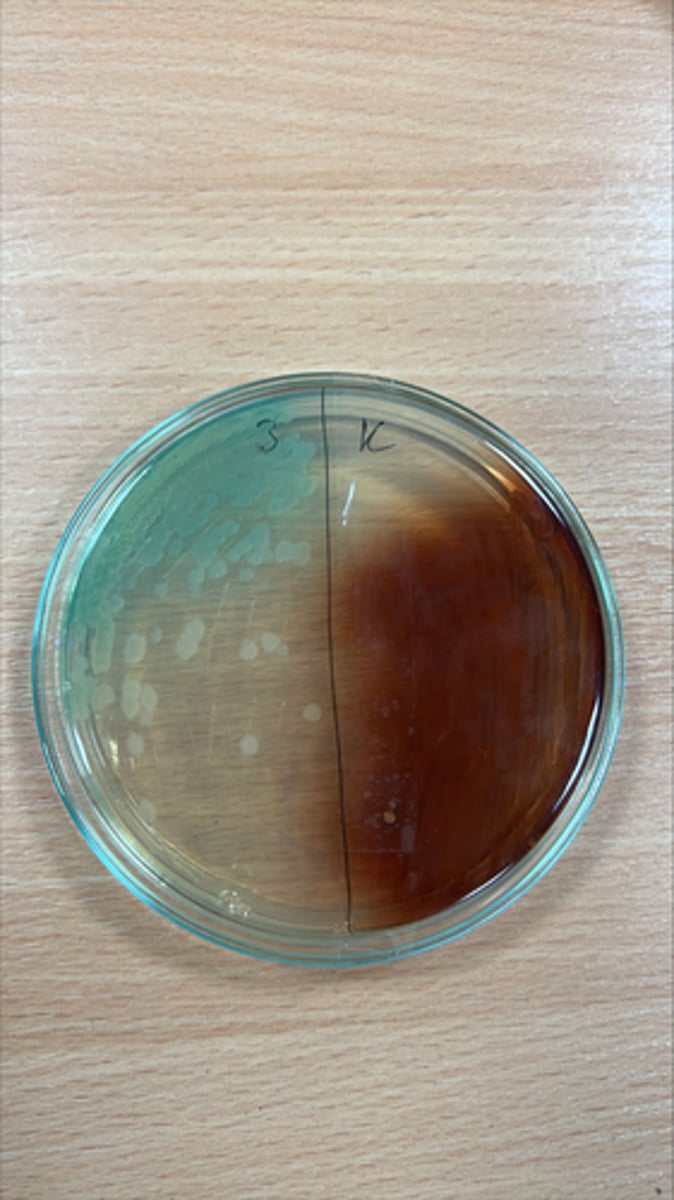
knowt flashcard image
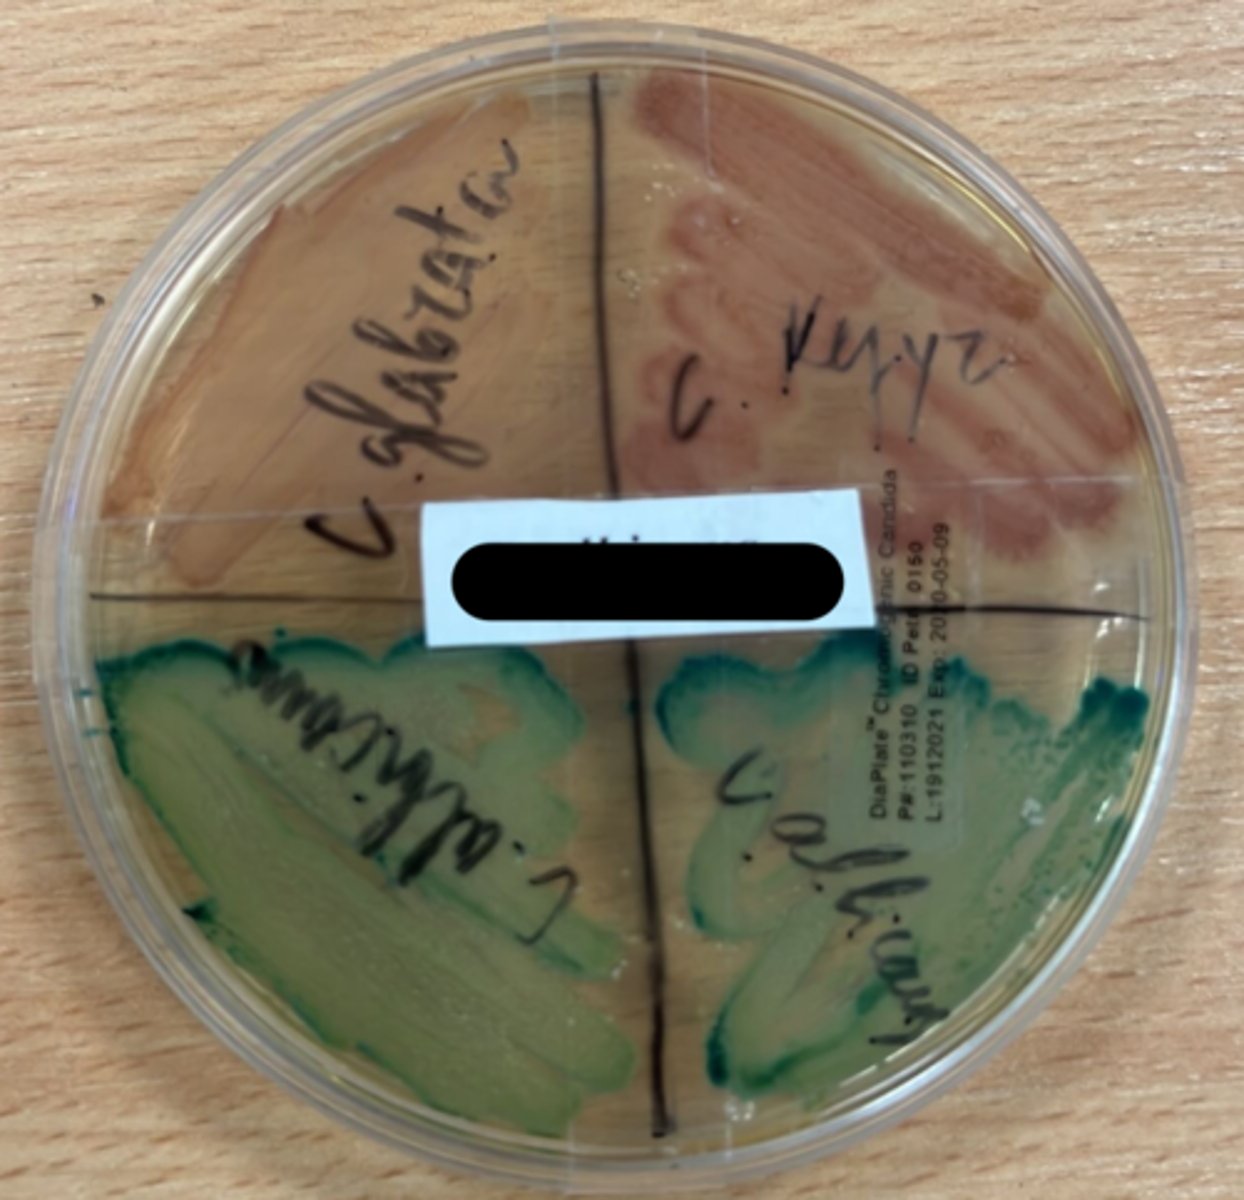
knowt flashcard image

1/42
Looks like no tags are added yet.
Name | Mastery | Learn | Test | Matching | Spaced |
|---|
No study sessions yet.
C.Perfringens
- Gram +
- Rectangular rods - spore forming
- Ziessler agar - anaerobic conditions
- Thioglycate broth - clear orange
- Disease: Gas gangrene, food poisoning
- Treatment - gas gangrene: penicillin; food poisoning: symptomatic treatment

H.Pylori
- Bright pink circles
- Helical rod
- Gram -ve
- Non-spore forming
- Glucose broth
- Blood agar * Antibiogram
- Disease: Duodenal/gastric ulcers, gastritis
- Treatment - Eradicate ulcer, antibiotics, protein pump inhibitor

H.Influenzae
- Coccobacilli
- Gram -ve
- Non spore forming
- Chocolate agar - grey/white colonies
- Thioglycate broth
Disease: Pneumonia, meningitis
- Treatment - ampicillin, Hib vaccine

C. Tetani
- Curbed purple rods - dense
- Gram +
- Non-motile, spore forming
- Blood agar/Ziessler agar
- Disease: tetanus, muscle spasm, lock jaw
- Treatment - Vaccine/Antibiotic (penicillin)

Y.Pestis
- Ovoid rods
- Gram -ve
- Non-spore forming
- Blood agar - grey/white colonies
- Disease: bubonic plaque (Black Death)
- Treatment - Tetracyclin/Strptomycin

Staphylococcus
- Cocci in groups
- Gram Positive
- Causes: TSS, Food poisoning
- Treatment by: Antibiotics or surgical
- Agar: Blood agar - gold/cream colonies

M. Tuberculosis
- Acid-fast staining
- Thin rods, non-spore forming
- TB
- Rough yellow colonies after 40 day incubation
- Drug treatment

Gram Negative Bacteria

N. gonnorhea
- Dark Blue kidney - diplococci
- Gram -ve
- Non-spore, non-motile
- Chocolate agar
- Thioglycate agar - Oxidase +, Glucose +
- Disease: Gonorrhoea
- Treat - antibiotic

M. Tuberculosis
- Acid-fast staining
- Thin rods, non-spore forming
- TB
- Rough yellow colonies after 40 day incubation
- Drug treatment

N. Meningitis
- Kidney shaped diplococci
- Non-spore
- Blood agar - grey colonies
- Chocolate agar - transparent colonies
- Thioglycate broth & Oxidase +ve
- Disease: Meningitis epidermis, pneumonia
- Treatment: Polyvalent vaccine & Penicillin

C. Albicans
- Cocci - small oval shape
- Gram +
- Green colonies in agar (candida chromagar)
- Saborou broth - yellow cream
- Diseases: Vaginitis, thrush, diaper rash

M. Tuberculosis
- Acid-fast staining
- Thin rods, non-spore forming
- TB
- Rough yellow colonies after 40 day incubation
- Drug treatment

B. Pertussis
- Red coccobacillary rods
- Gram -ve
- Non-spore forming
- Bordet genau agar
- Broth - glucose +ve
- Disease: Whooping cough - Catarrhal (2wks), Paroxysmal (4wks), Convalescent (4wks) stages
- Treatment: Antibiotics at Catarrhal stages, then sedatives at severe

S. pneumoniae
- Lanced diplococci
- Gram +ve
- Blood agar - Green tinge
- Inlunin +ve broth
- Disease - Bronchial/lobar pneumonia, middle ear infection, meningitis
- Treat: Antibiotics (penicilin, erythromycin)

M. Tuberculosis
- Acid-fast staining
- Thin rods, non-spore forming
- TB
- Rough yellow colonies after 40 day incubation
- Drug treatment

V. Cholerae
- Small curved rods
- gram -ve
- Non-spore
- TCBS agar - green w/yellow colonies
- Disease: Severe diarrhoea - hypovolemic shock
- Treat - rehydration, IV fluid, antibiotics

M. Tuberculosis
- Acid-fast staining
- Thin rods, non-spore forming
- TB
- Rough yellow colonies after 40 day incubation
- Drug treatment

B. Anthracis
- Rods in chains - spore forming
- Gram Positive
- Simple agar - medusa head
- Simple broth - cotton like sediments
- Diseases: Cutaneous anthrax, GI anthrax, Pulmonary anthrax, meningitis
- Treatment: Antibiotics

Streptococcus
- Cocci
- Gram +ve

Diptheriae
- Clubbed rods
- Gram +ve
- Loeffler medium broth - thick creamy - Glucose +ve, Maltose +ve
- Disease: Pharyngitis, pseudomembrane in throat, Heart failure
- Treatment - Antibiotics (erythromycin/Penicilin)/Vaccine

Blood Agar, Bordet-Genau, Zeissler - If this comes up, best to just say Blood agar, there is no way of actually differentiating between the 3

Levin agar
(Dark red)

Apoholacitrate agar - on right with H2S Positive black spots

Chocolate agar

S. Aureus

Satellitism test

Antibiogram
P. aeruginosa

P. aeruginosa

Klauberg III

C. albicans

Rice agar

TCBS

alkaline agar

B. anthracis

P. aeriginosa in simple agar
proteus - wavy appearance

Loeffler medium

C. xerosis

N. gonorrhoeae

M. tuberculosis

C. albicans in chromagar media